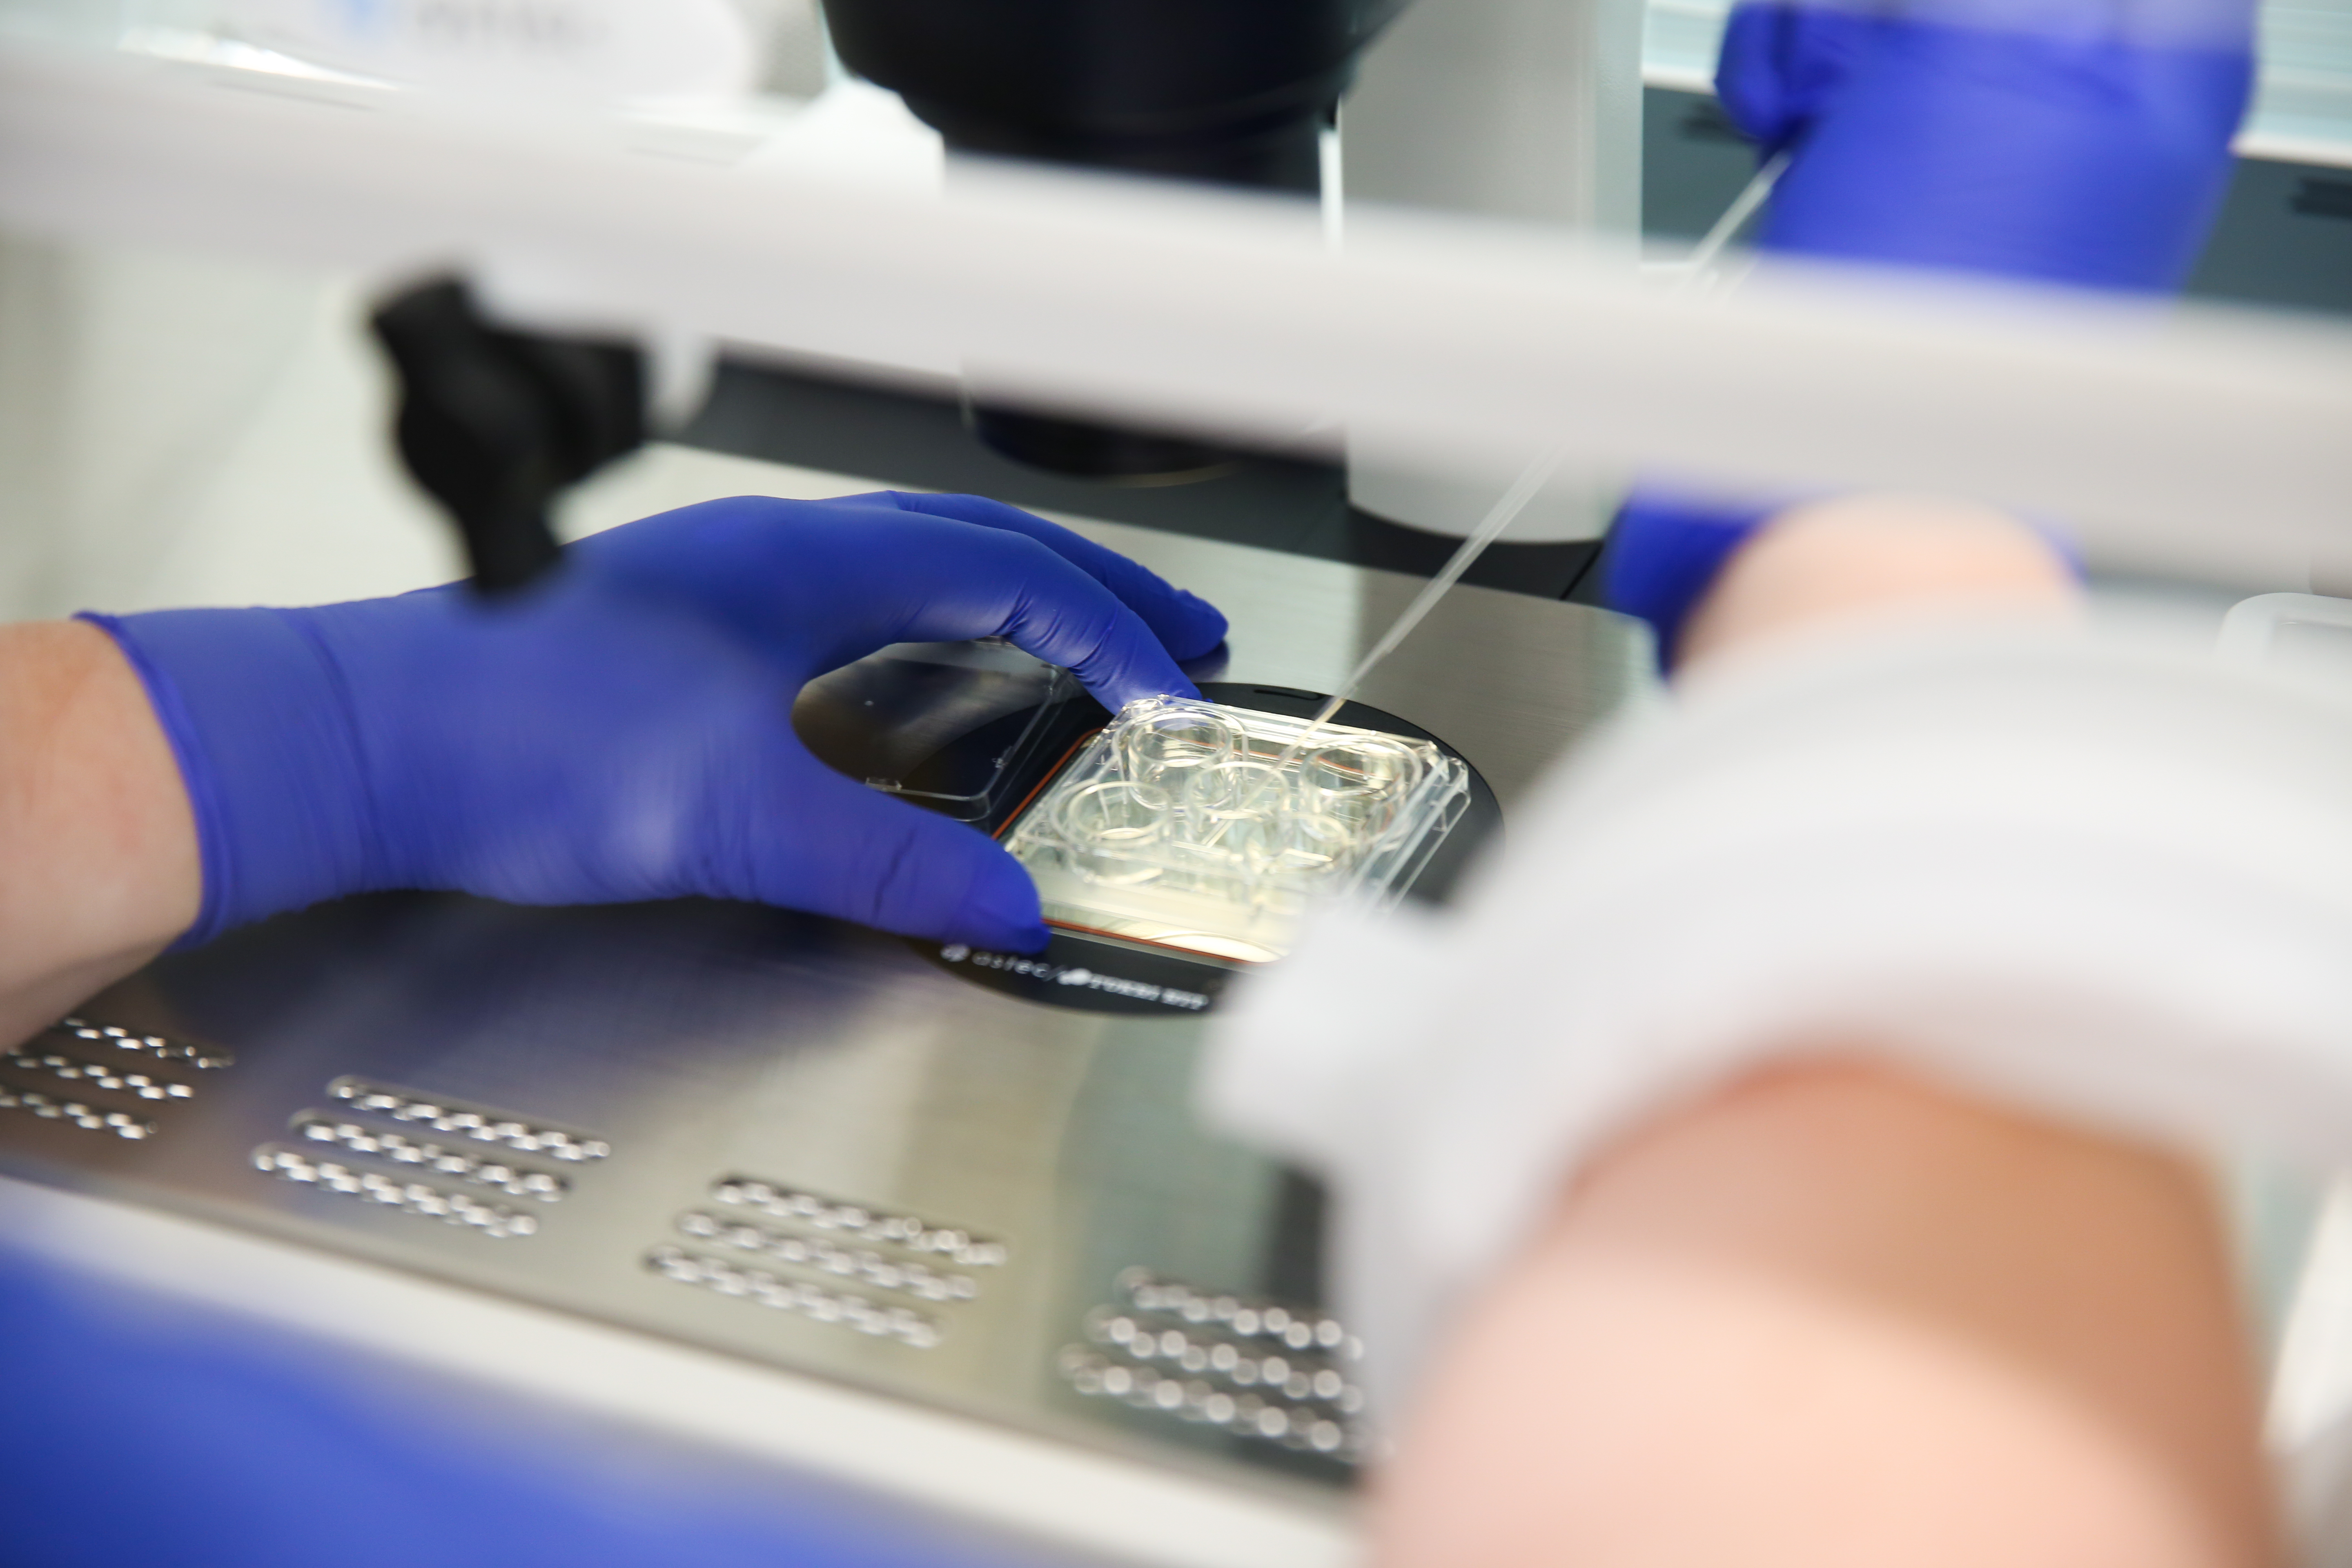

随着体外受精科研技术的日新月异,许多体外受精诊所得以不断改进治疗方案以及胚胎的处理过程,从而提升受孕成功率。
在城市助孕中心,我们一直关注体外受精实验技术的最新发展,以确保我们能够继续为患者提供享誉国际的顶尖服务。
我们自从在悉尼开设城市助孕中心的实验室,就引进了最尖端的技术。我们除了联合使用最新的延时摄影技术以及引领全球的胚胎培养技术,还透过洁净技术,掌控温度和空气质量,确保卵子和胚胎受破坏的机率大幅度降低。在各项博大精深的技术当中,我们在此献上三项技术的简介,与您分享。

EmbryoScope
EmbryoScope是一项延时摄影技术,在胚胎的发育过程中,全程不间断采集图像,确保胚胎在不受干扰的环境下成长,减少因处理不当而造成的伤害。
特别设计的EmbryoScope培养箱内置摄像头和显微镜,每十分钟拍摄一次胚胎的图像。胚胎存放在培养箱中的两到五天内,我们将得到个别胚胎的延时视频。随后,透过先进的软件,我们可获取胚胎发育的信息,从而选择最好的胚胎,以展开助孕疗程。

洁净实验室
在受控的正压环境里,我们采用了高效空气过滤器以及活性炭过滤系统,因此,足以影响胚胎发育的挥发性有机物、醛类物质、细菌和真菌孢子以及所有颗粒物几乎变得荡然无存,实验室的空气管理也达到最高的洁净标准。
越来越多证据显示,体外受精疗程要取得最佳成效,实验室的空气质量至关重要。我们的系统可净化培养箱和实验室内的空气质量,从而促进胚胎和细胞的良好发育。

遗传学检测
我们的实验室提供专业的胚胎植入前遗传学筛查,以检测胚胎中的染色体数目或结构是否有异常。透过遗传学检测,我们可进行高级胚胎筛选,即筛选出最理想的胚胎,以进行移植。我们提供的遗传学检测分为两大类:
胚胎植入前遗传学筛查
胚胎植入前遗传学筛查的目的不是诊断任何特定的疾病,而是为了筛查胚胎的染色体结构。如果胚胎染色体数目畸变(称为非整倍体状态),比如缺少了一条染色体,那胚胎细胞就会缺少一整套指令。另一方面,如果染色体过多,细胞就会因为过分遵循这些指令而变得失常,从而引发唐氏综合症等病症。

胚胎植入前遗传学诊断
胚胎植入前遗传学诊断是一种先进的单基因检测。如果患者有单基因遗传病家族史,所产生的胚胎很可能受其影响,则适合接受该检测。以目前的技术,胚胎植入前遗传学诊断可以检测出的病症包括囊肿性纤维化、β地中海贫血症、地中海贫血症、脊髓性脑萎缩症与脊髓性肌肉萎缩症,以及可引发遗传性乳腺癌和/或卵巢癌的乳腺癌1号基因/乳腺癌2号基因。
整体而言,我们的组织实力雄厚,助孕专科医师团队阵容强大,而科研领导团队更有60余年的综合经验,必能献上最好的疗程与护理,并全程伴随着您,让您高枕无忧。
我们的实验室设在城市助孕中心的最新诊所内,位于悉尼中央商务区的环形码头,地点适中。该诊所也是澳大利亚最先进的体外受精诊所之一。
欲知我们所提供的服务以及体外受精实验室的更多信息,请致电 1300 354 354 或发送电子邮件至 [email protected],联系我们的助孕咨询团队。
也請訪問我们的官网https://www.cityfertility.com.au/clinics/sydney-cbd/
